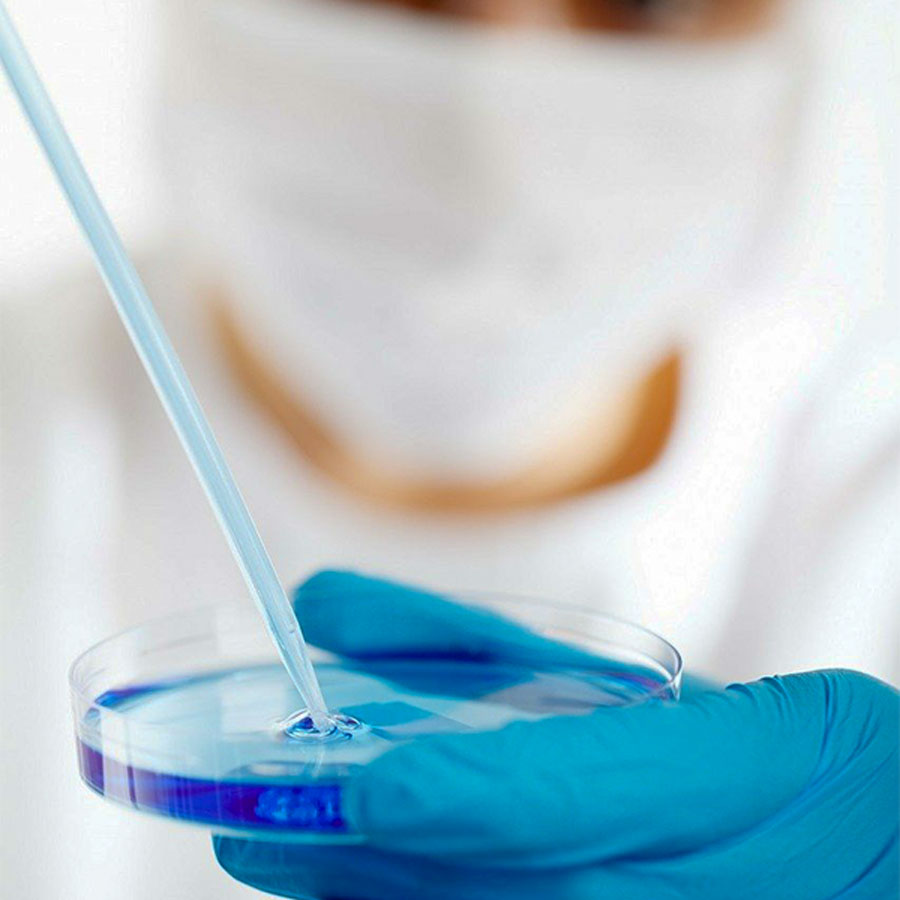
Coronavirus. Italia: calano per la prima volta i positivi in isolamento domiciliare

Dei 105.847 malati complessivi per Coronavirus, 21.533 sono ricoverati con sintomi, 535 in meno rispetto a ieri, e 82.212 sono quelli in isolamento domiciliare, in calo per la prima volta dall’inizio dell’emergenza di 74 pazienti.
Il dato è stato reso noto dalla Protezione civile nel monitoraggio sanitario relativo alla diffusione della pandemia sul nostro territorio.
A oggi, 25 aprile, il totale delle persone che hanno contratto il virus tra positivi, guariti e deceduti è di 195.351con un incremento rispetto a ieri di 2.357 nuovi casi. Prosegue il trend a ribasso delle Terapie intensive – 71 pazienti rispetto a ieri su su 2.102 pazienti, stesso valore per i ricoverati con sintomi che hanno subito un decremento di i 535 pazienti rispetto a ieri su 21.533 casa.
Rispetto a ieri i deceduti sono 415 e portano il totale a 26.384. Il numero complessivo dei dimessi e guariti sale invece a 63.120, con un incremento di 2.622 persone rispetto a ieri.
Nel dettaglio, i casi attualmente positivi sono 34.473 in Lombardia, 12.347 in Emilia-Romagna, 15.502 in Piemonte, 9.432 in Veneto, 6.146 in Toscana, 3.433 in Liguria, 3.272 nelle Marche, 4.561 nel Lazio, 2.935 in Campania, 1.744 nella Provincia autonoma di Trento, 2.919 in Puglia, 1.084 in Friuli Venezia Giulia, 2.272 in Sicilia, 2.061 in Abruzzo, 1.035 nella Provincia autonoma di Bolzano, 297 in Umbria, 794 in Sardegna, 811 in Calabria, 313 in Valle d’Aosta, 218 in Basilicata e 198 in Molise.
© Tutti i diritti riservati